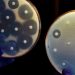
Antimicrobial Resistance

This article was originally published by The Defender — Children’s Health Defense’s News & Views Website.
Agribusiness watchdog OrganicEye today demanded the U.S. Department of Agriculture (USDA) hold a public hearing — or face litigation — on the use of mRNA and other genetically engineered vaccines in organic livestock production. The use of such genetically modified products violates the legal definition of “organic,” the group said.
The request comes after reports that the USDA and some organic certifiers have “quietly looked the other way” as commercial livestock producers have begun using genetically engineered vaccines in animals producing organic-certified meat, eggs and dairy products, according to OrganicEye.
One of the most important differences — perhaps the key difference — between conventional and organic food is the organic label’s strict prohibition on genetically modified farm inputs and ingredients, as laid out in the Organic Foods Production Act of 1990.
OrganicEye said that rather than enforcing this rule, the USDA has sanctioned a “don’t ask, don’t tell” protocol — pushed by Big Ag — that allows producers to administer genetically engineered vaccines to animals and still label them “organic.”
The issue is urgent, according to Mark Kastel, executive director of Wisconsin-based OrganicEye, because of the imminent use of mRNA vaccines for livestock, which are currently being developed with massive funding from government and industry.
“The impetus for us to act now is the impending introduction of vaccines for livestock produced using mRNA technology similar to that used by Pfizer and Moderna to produce their respective versions of the SARS-CoV-2 vaccine,” Kastel stated.
“There is a continuing controversy in the country concerning this new technology and we should work to preserve organics as the last safe haven for eaters who want to secure a truly ‘natural’ diet,” he added.
It is “unacceptable,” the nonprofit stated, for the USDA to “kick the can down the road” on this highly controversial issue.
OrganicEye is calling on the USDA’s National Organic Standards Board (NOSB) to convene a meeting of all stakeholders, not only with industry interests who want these vaccines, Kastel told The Defender, but also with “people who have a concern — whether they’re farmers that don’t need them and feel they’re being competitively injured by competing against these livestock factories, or whether they’re consumers who have a general concern about genetic engineering and the food supply.”
“They have a right to be heard,” he said.
A corrupted oversight process
Synthetic materials are by default banned in organics, unless they have been explicitly permitted because they are deemed “essential” to production and have been evaluated and determined to be safe for human health and the environment.
Congress created the NOSB in the 1990s to recommend industry standards for regulating such materials. It is a powerful advisory board — the USDA cannot allow any synthetic substances in organic production unless the NOSB has explicitly approved and recommended them.
The board was designed to represent stakeholders from across the organics industry, including small farmers and consumers, but it has increasingly become dominated by powerful agribusiness lobbyists — and as a result, increasingly subordinate to agribusiness’ dictates.
The first question that must be investigated, Kastel said, is whether vaccines are “essential” for livestock at all. They are generally not required in livestock production “other than some state regulations pertaining to interstate transportation of livestock,” he said.
But many producers, particularly in industrial agriculture, vaccinate their animals anyway to “mitigate risks.” Kastel said a hearing would allow the public to investigate whether “there’s any good justification coming from anybody other than people involved in conventional livestock production for the use of vaccines.”
Or, maybe animals “maintained in a healthy environment with plenty of outdoor access and pasture for ruminants like beef and dairy cows on family-scale farms,” don’t need any vaccines at all — let alone genetically modified ones, he said.
Many vaccines previously approved for organic production have been phased out and replaced with vaccines produced through genetic modification.
At recent NOSB meetings, accredited organic certifiers admitted that they do not check to see whether vaccines used violate the prohibition against genetic engineering — despite the fact that federal regulations mandate their review.
In response, the NOSB recommended the USDA approve a regulatory amendment allowing for the use of these genetically modified vaccines in organic production in cases where the traditionally produced vaccine was no longer available.
In a policy brief also released today, OrganicEye called this move “likely illegal” because “in all cases, vaccines produced using methods of genetic engineering/modification are clearly forbidden by the national organic standards and are currently excluded from use.”
The USDA did not enact that recommendation and has stated it won’t act in this regulatory area. In other words, Kastel said, the USDA is saying they “have no intention to do new rulemaking,” and are instead letting things stand — taking a “don’t ask, don’t tell,” approach to regulating GMO vaccines.
Dr. Hubert Karreman, doctor of veterinary medicine, North Carolina dairy farmer, charter fellow of the American College of Veterinary Botanical Medicine and former NOSB member, said that instead, the USDA could and should “create a very clear, easily understandable categorization system such that organic farmers don’t use a genetically engineered vaccine by mistake.”
OrganicEye charges the USDA’s reluctance to create that system is due to the influence of “powerful lobbyists and industry interests, mostly with expertise in conventional livestock production as in the case of vaccines,” who have an interest in producers continuing to rely on vaccines, rather than “providing more healthful and secure living environments for domesticated animals.”
In its policy brief, OrganicEye proposed the USDA create a clear categorization for vaccines, review all vaccines for safety prior to approval — including for the persistence of “foreign” DNA, RNA and antibodies in meat — and develop a way to deal with concerns that arise from that review, including removing such vaccines from the market if need be.
OrganicEye is also promoting a campaign to put pressure on the Biden administration to reduce its dependence on political appointees from corporate agribusiness in organic regulatory oversight — a practice that has resulted in the legally questionable conduct the group is protesting.
Veterinarians: ‘Not enough known’ about long-term effects of mRNA vaccines for livestock
“The successful application of mRNA vaccines against COVID-19 has further validated the platform and opened the floodgates to mRNA vaccine’s potential in infectious disease prevention, especially in the veterinary field,” according to a study published last year in the journal Viruses.
But, Kastel said another reason for holding a public hearing is that there are many open questions about the safety of mRNA vaccines for animals and humans.
Dr. Max Thornsberry, R-CALF USA animal health committee chair, said in an April briefing for R-CALF USA, a nonprofit representing the interests of independent U.S. cattle producers, that research has shown mRNA likely passes to humans who have consumed products from an mRNA-injected animal.
Research published in JAMA also shows the persistence of COVID-19 antibodies in the human breast milk of vaccinated mothers. And recent research showed that Moderna recommended against vaccination of nursing mothers.
This raises questions, Kastel said, about how animals injected with GMO vaccines, particularly for diseases that don’t even affect humans, might introduce new antibodies into the human food supply. The associated risks need to be studied and evaluated, he said.
Thornsberry added that mRNA research is “still in its infancy, no one really knows the full impact it has on either humans or animals, particularly its long-term impact,” and that it, therefore, warrants greater research on safety and greater transparency.
Holistic veterinarian Dr. W. Jean Dodds told The Defender in January that, “Not enough is known at this time if mRNA vaccines can generate any long-term effects on reproduction or lifespan of domestic farm stock.”
“As livestock become part of the human and animal food chain, we need to be sure that no abnormal cellular or molecular changes to the animal could be induced by this type of vaccine,” Dodds added.
GMO vaccines already in use, but ‘no way for consumers to know’
Concerns that mRNA injections could end up in animal products meant for human consumption prompted warnings from cattle producers and calls for mandatory country of origin labeling so consumers can choose meat from countries that don’t allow mRNA shots in meat animals.
Backlash quickly ensued, with legacy media painting the concerns as “conspiracy theories,” “fearmongering” and “misinformation,” and issuing a series of misleading “fact checks.”
But several new government- and industry-funded studies are, in fact, already underway to develop mRNA vaccines for livestock, part of the massive expansion of the animal vaccine industry projected to be worth at least $26.12 billion by 2030.
Researchers at Iowa State University are undertaking a project funded by the USDA to develop mRNA vaccine technology to prevent bovine respiratory syncytial virus.
Pharmaceutical company Zoetis developed an mRNA COVID-19 vaccine for animals that was administered to animals at zoos throughout the country.
And researchers in the U.S. Fish and Wildlife Service experimented with vaccinating captive-bred black-footed ferrets against COVID-19. They also experimented with social distancing and quarantine of ferrets.
“Third-generation vaccines,” including DNA, RNA and recombinant viral vector vaccines, are not only currently administered to livestock — they also are being developed for companion animals and wild animals.
Merck Animal Health has for several years marketed a “customizable vaccine” made with “RNA particle technology” to make swine flu and other virus vaccines customized to specific animal herd needs. And the USDA allows two “DNA” novel vaccines and avian influenza vaccine for poultry and a swine influenza vaccine.
Citing the need for biosecurity, in September 2022, the New South Wales government fast-tracked the world’s first mRNA vaccines for foot-and-mouth disease and lumpy-skin disease, in a five-year multimillion-dollar deal with U.S. biotech company Tiba Biotech.
There is no way for consumers to know whether genetically engineered vaccines are being used in livestock to produce USDA-certified organic meat, eggs or milk. People have a right to this information, Kastel insisted. They also need to know, he said:
“Is there any deleterious impact? Is it essential? Is it safe? And right now, because GMO vaccines are not legal [in organics], is there really no alternative to them?
“Or is that just the spin from the livestock and biotech industry that wants to change over to GMO vaccines?”
This article was originally published by The Defender — Children’s Health Defense’s News & Views Website under Creative Commons license CC BY-NC-ND 4.0. Please consider subscribing to The Defender or donating to Children’s Health Defense.
Discover the Freedom of True American Healthcare: Why America First is Revolutionizing Protection for Patriots
In a world where government overreach and skyrocketing premiums are squeezing the life out of hardworking Americans, one innovative agency is standing tall for liberty and affordability. Meet America First Healthcare—the private health insurance powerhouse dedicated to putting *you* first.
Founded by entrepreneur Jordan Sarmiento, this isn’t just insurance; it’s a shield for your family’s future, built on the unshakeable belief that private enterprise delivers better results than bureaucratic red tape.
Picture this: Jordan’s own story hits close to home for so many of us. A sudden medical emergency landed him with a staggering $95,000 bill. Under a traditional plan? He’d be buried in debt. But with America First’s patented health insurance, that nightmare shrank to just $500 out-of-pocket. That’s not a fluke—it’s the promise of coverage that works *for you*, from day one.
Breaking Free from the Chains of Conventional Coverage
Let’s face it: The status quo stinks. Marketplace.gov and big-insurance behemoths hit you with sky-high deductibles—thousands you’d have to pay before benefits even kick in—leaving massive holes in your protection. Need a routine mammogram, colonoscopy, or EKG? Good luck without forking over more cash. And don’t get us started on the gaps in dental, vision, or critical illness support when heart attacks, cancer, or kidney failure strike.
America First Healthcare flips the script. As a proud advocate for private solutions over government intervention, they craft custom plans that slash costs by 20% compared to traditional options. We’re talking comprehensive coverage that includes:
- Preventative and Wellness Care: Physical exams, screenings, and EKGs covered right away—no waiting games.
- Telemedicine Access: Virtual doctor visits anytime, anywhere, for that peace of mind.
- Accident and Critical Illness Protection: Real safeguards against life’s curveballs.
- Add-On Boosts: Dental, vision, disability, and supplemental plans to plug every leak.
Whether you’re an individual stepping off your parents’ plan, a growing family with kids in tow, or a small business owner tired of employee headaches, their tailored approach fits like a glove. Small businesses? Unlock group benefit rates usually reserved for corporate giants—without the red tape.
And for those in-between moments? Short-term insurance steps in as an ultra-affordable bridge, while life insurance ensures your loved ones are never left vulnerable.
Real Americans, Real Wins
Don’t just take our word for it. Thousands of freedom-loving families have already ditched the old system for America First. “Finally, insurance that aligns with our values and actually saves us money,” shares one client. Another raves, “Our small team got big-business perks without the hassle—it’s a game-changer.” These aren’t scripted lines; they’re the voices of patriots who’ve reclaimed control over their health destiny.
Your Move: Secure Your Shield Today
Why settle for less when you can demand better? America First Healthcare isn’t about profits—it’s about powering the American dream with reliable, value-driven protection. Plans are available year-round, no open-enrollment nonsense.
Ready to uncover the gaps in your current setup and lock in savings? Schedule your FREE healthcare review today at America First Healthcare. In under 15 minutes, their experts will map out options that fit your life, your budget, and your principles.
America First isn’t just healthcare—it’s a declaration of independence. Join the movement. Your family’s freedom starts now.